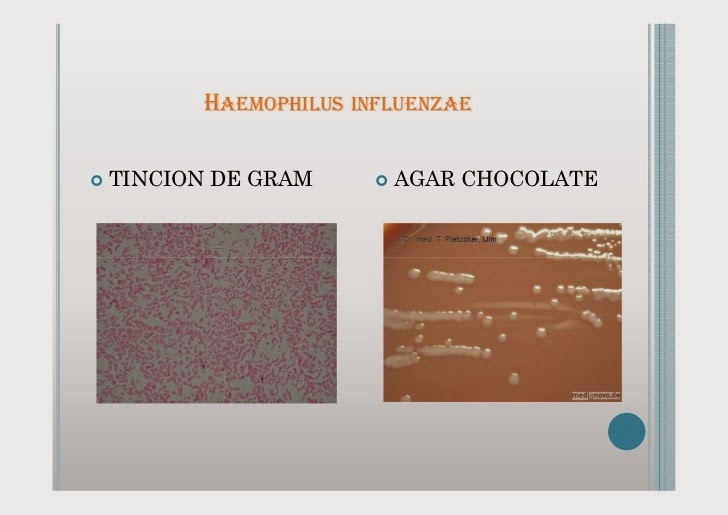
Fta Abs Anticorpos Igg Reagente O Que Significa - The Portuguese Blog

WebOlá. Esse exame positivo que você tem ou teve sífilis. Mesmo que você tenha feito o tratamento, esse exame ficará sempre positivo e nunca mais negativará. É a cicatriz sorológica. Se você nunca realizou um tratamento, procure seu médico para tratar a. WebPARA QUE SERVE O TESTE FTA-ABS PARA SÍFILIS? O teste FTA-Abs, é um teste sorológico e específico para detectar os anticorpos que são produzidos contra o. WebAinda existem dois tipos de resultados para o FTA-ABS, que são as imunoglobulinas M e G. No caso de doença recente ou em atividade, o FTA-ABS IgM estará reagente; no caso.
Fta Abs Igg Reagente O Que Significa, Sífilis: o exame FTA-ABS, 7.3 MB, 05:19, 13,260, Dr. Claudio Mussi - Urologista, 2020-09-20T13:45:15.000000Z, 3, FTA-ABS Test: Principle, Procedure, Results • Microbe Online, microbeonline.com, 508 x 562, png, fta test abs principle treponema procedure antibody fluorescent pallidum absorption sorbent interpretation microbeonline results cultures extract note reiter antibodies, 20, fta-abs-igg-reagente-o-que-significa, KAMPION
WebO FTA - ABS IgG e IgM significam que você tem ou teve sifilis. Enquanto o IgM representa uma infecção mais recente, o IgG significa uma infecção tardia. Após ter. WebAinda existem dois tipos de resultados para o FTA-ABS, que são as imunoglobulinas M e G. No caso de doença recente ou em atividade, o FTA-ABS IgM estará reagente; no caso. WebO que significa sífilis FTA-ABS IgG reagente? O resultado do exame de Sifilis FTA-ABS-IGG, foi reagente 1:10, o que significa? Olá. Esse exame positivo que você. WebO resultado IgG reagente para toxoplasmose significa que existem anticorpos circulantes na corrente sanguínea contra o T. gondii, que é o parasita responsável pela doença, o que. WebSe o seu exame de FTA - ABS IgG e IgM vieram negativos ou não reagentes, você nunca teve sífilis. Após o contato sexual de risco, este exame ficará positivo em 10. WebIgM não reagente e IgG reagente. Um resultado IgM não reagente e IgG reagente indica que você já foi exposto ao antígeno, seja por uma infecção passada ou. WebOs testes mais utilizados são o VDRL (teste antigênico não treponêmico) e o FTA-ABS (teste treponêmico). Confira as diferenças entre esses dois exames: A prova. WebO FTA-ABS IgG e IgM significam que você tem ou teve sifilis. Enquanto o IgM representa uma infecção mais recente, o IgG significa uma infecção tardia. Após ter sífilis, mesmo.
Atualmente - Sífilis: o exame FTA-ABS
Último Sífilis: VDRL e FTA-ABS Novo
Assista O que significa IgG reagente e IgM não reagente #drdiegodimarco #imunidade #igg #igm Novo
Detalhes Fta Abs Igg Reagente O Que Significa que pode ser interessante
Vídeo 50
O FTA-ABS (fluorescent treponemal antibody absorption) não é o único teste treponêmico disponível no mercado, mas é um dos mais utilizados e iremos falar neste vídeo um pouquinho sobre ele.
Dr. Claudio Mussi é médico urologista em Foz do Iguaçu – Paraná
CRM: 9526
RQE: 3085
Sífilis:
youtube.com/playlist?list=PLV3KjM9X_E0_-eJuwK6ulfH10a4y9OdV8
IST (Infecções Sexualmente Transmissíveis):
youtube.com/playlist?list=PLV3KjM9X_E0_6FznYDgYRlnTd5HZnTwxy
Região genital:
youtube.com/playlist?list=PLV3KjM9X_E09Ej1CZ5fRjoq0rUXqtHzs4
Bibliografia:
Campbell-Wash – Urologia. Rio de Janeiro: Elsevier, 2019
Smith e Tanagho – Urologia geral. Porto Alegre: AMGH, 2014
AVISO LEGAL:
Todos os dados disponibilizados pelo canal têm apenas o único objetivo de melhor informar, não tendo o propósito de sugerir tratamentos e nem de substituir um profissional habilitado. O autor se exime de qualquer responsabilidade legal advinda da má utilização das informações aqui transmitidas. Em caso de dúvidas, procure um profissional habilitado, não realizo consultas e nem dou aconselhamento médico por aqui.
Atualmente - FTA-ABS Test: Principle, Procedure, Results • Microbe Online

Notícias IFT FTA-ABS IgG pos.Kontrolle 1mL

Assista PPT - Các xét nghi?m ch?n ?oán b?nh giang mai PowerPoint Presentation mais

Artigos FTA-ABS - Para Que Serve Este Teste? Anticorpos IgM + IgG (Sífilis se tornando viral

Atualmente - Fta-Abs - Para Que Serve Este Teste? Anticorpos Igm + Igg (Sífilis popular

Discussão MASTAFLUOR FTA-ABS IgG, Treponema pallidum

Assunto FTA ABS IgG ANTIBODY IF KIT tendência

Assunto Teste FTA-ABS - YouTube atualizado

Sobre Practica FTA ABS

Atualmente - Fta Abs Anticorpos Igg Reagente O Que Significa - The Portuguese Blog viral

0 komentar: